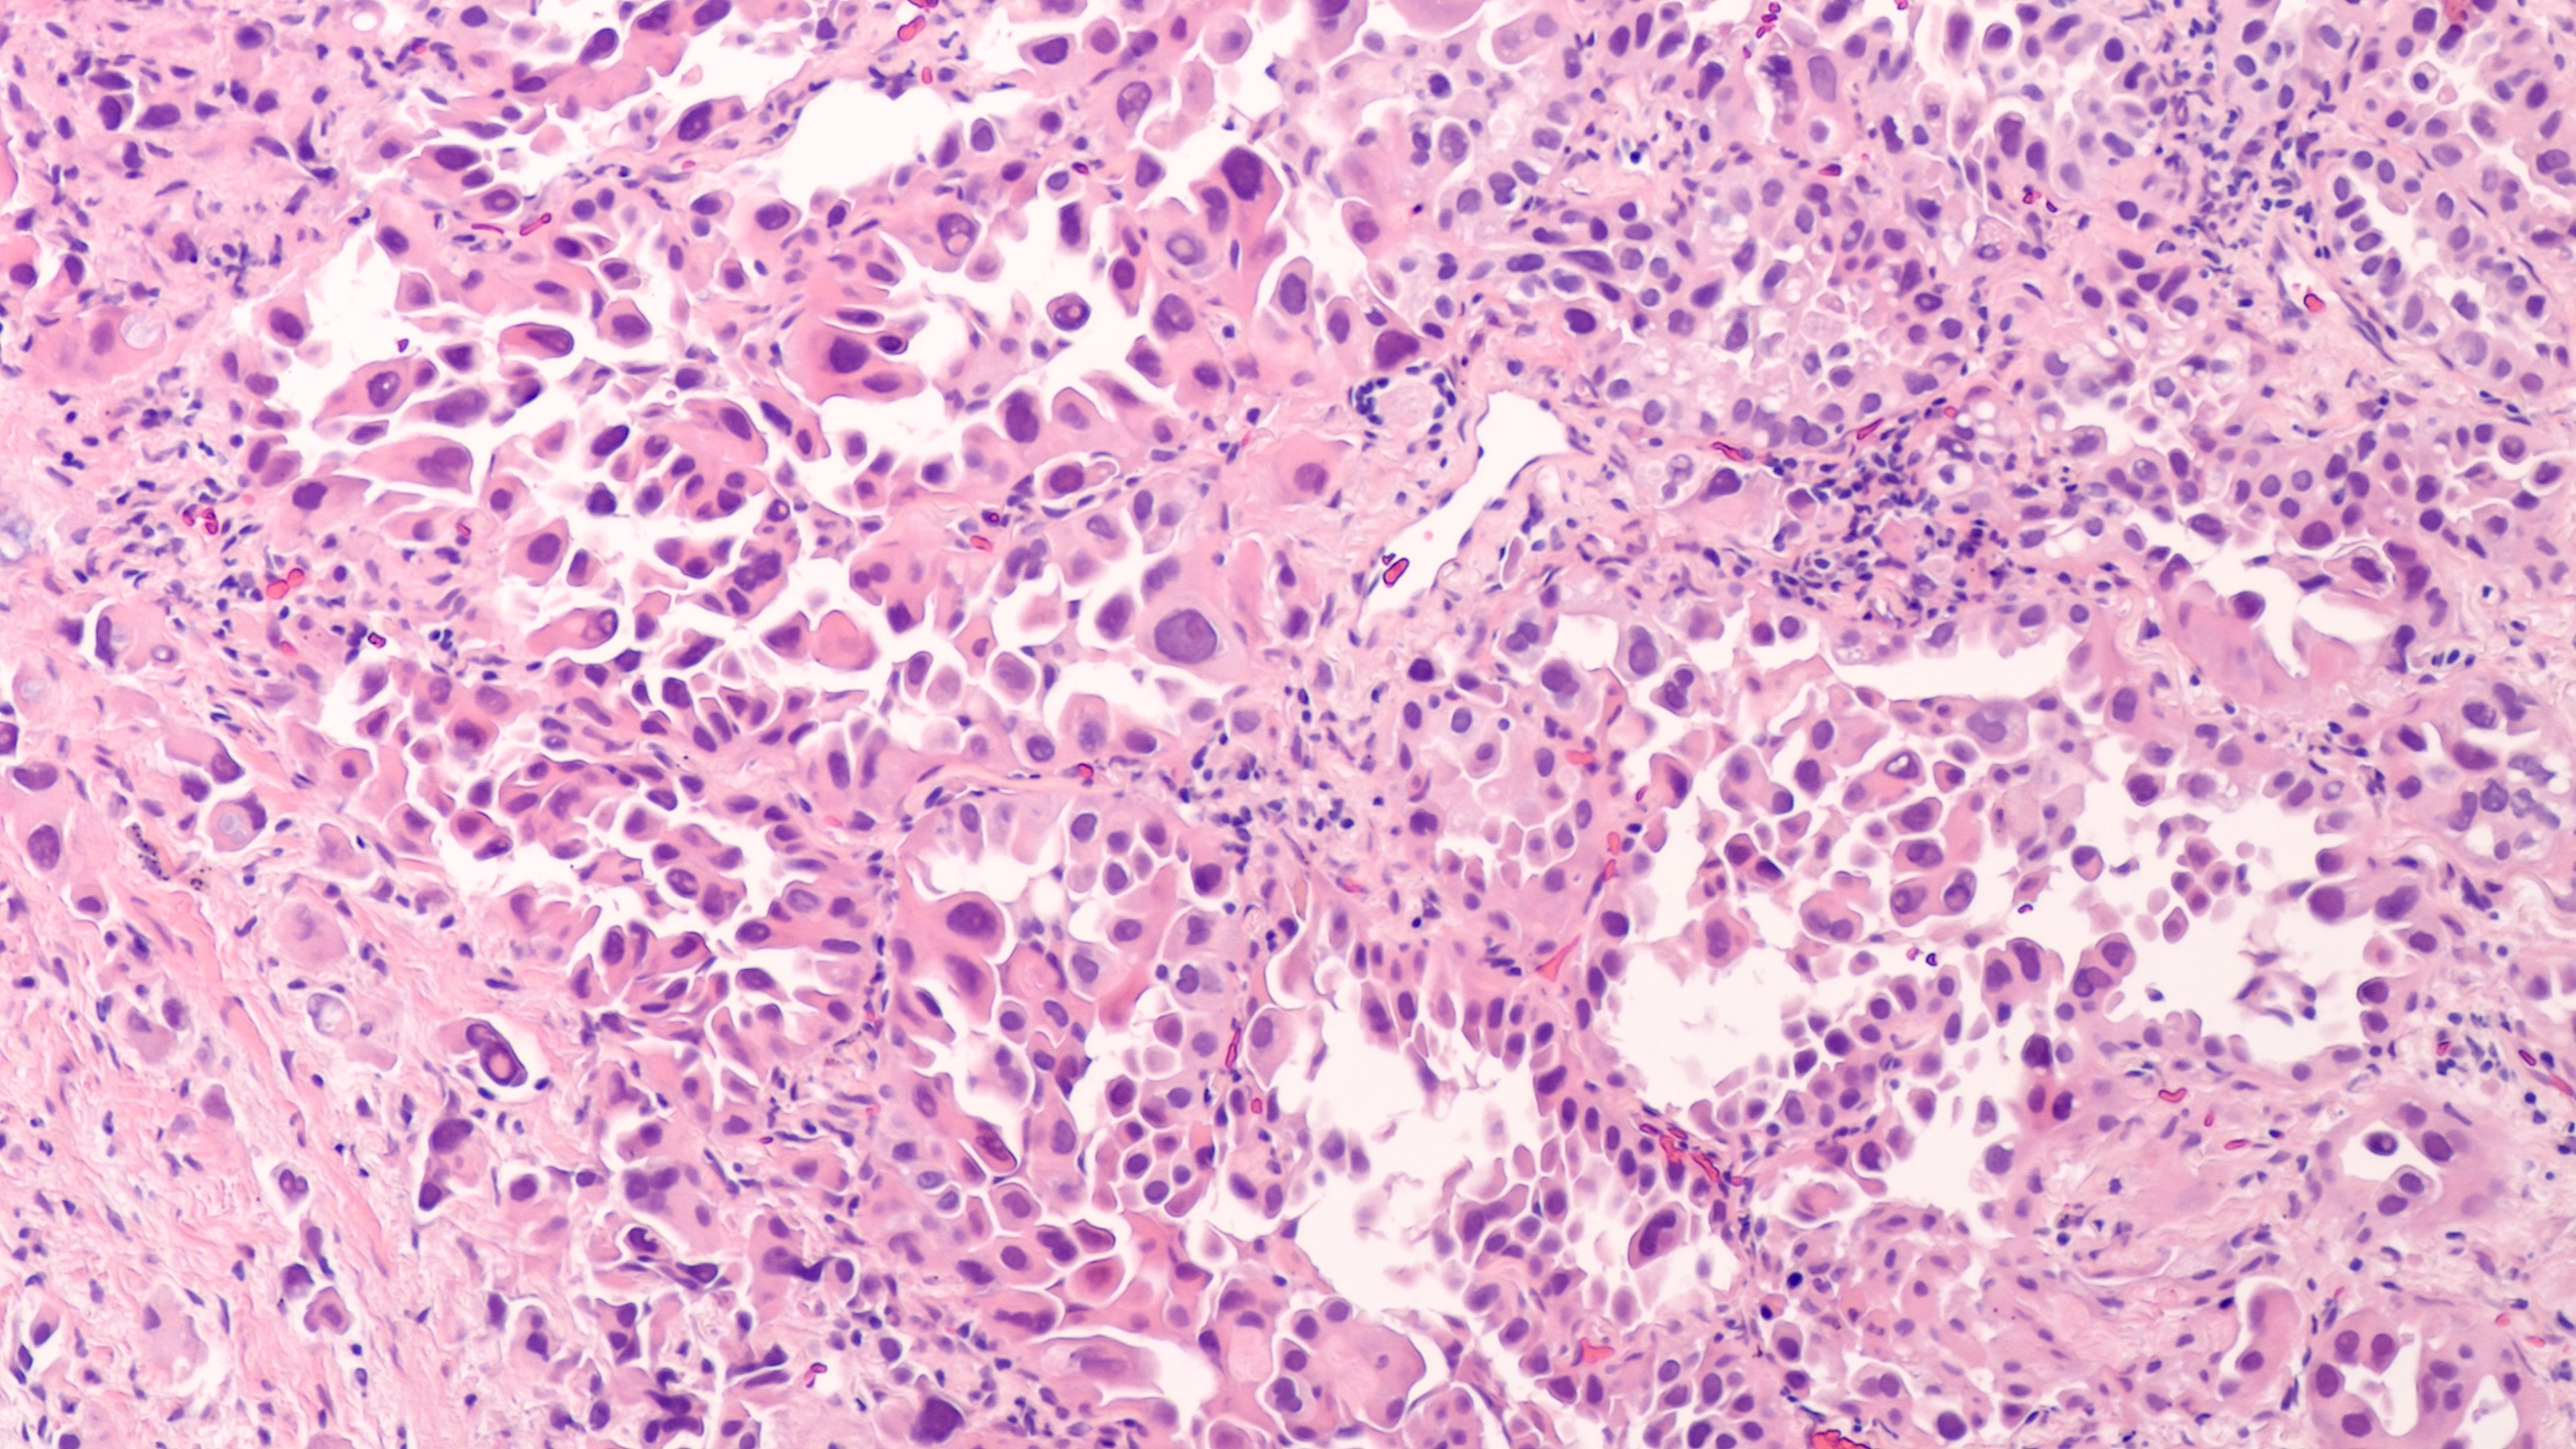

Uncommon EGFR mutations in non–small cell lung cancer (NSCLC) remain challenging to treat, but new tyrosine kinase inhibitors, bispecific antibodies, and a proposed “PACCage insert” framework provide opportunities to advance precision therapy.
Uncommon EGFR mutations, such as exon 20 insertions, compound variants, and P-loop αC-helix compressing (PACC) alterations, account for nearly one-third of all EGFR-driven non–small cell lung cancer (NSCLC), yet effective treatment strategies for these diverse subgroups are still evolving, explained Aaron C. Tan, MBBS, PhD, FRACP, at the 2025 World Conference on Lung Cancer (WCLC) in Barcelona, Spain.
Although the classical activating EGFR mutations, such as exon 19 deletions and exon 21 L858R point mutations, are well established in guiding the use of tyrosine kinase inhibitors (TKIs), there remains substantial heterogeneity within the broader category of EGFR alterations.1
Tan, a medical oncologist at the National Cancer Centre Singapore, provided a comprehensive overview at WCLC of the current and emerging therapeutic options for patients with uncommon EGFR mutations and exon 20 insertion–mutated NSCLC. During his presentation, Tan explored the biology of these alterations, highlighted approved therapies, and reviewed key clinical trial data for emerging agents. He also proposed the conceptual “PACCage insert” framework to help clinicians classify EGFR mutations and align patients with optimal therapeutic strategies.1
Uncommon or atypical EGFR mutations include exon 20 insertions, single rare substitutions, and complex compound variants. Together, these mutations comprise a substantial proportion of EGFR-driven disease, with estimates suggesting they represent up to 30% of all EGFR mutations, according to Tan.1
The emergence of novel TKIs, bispecific antibodies, and structure-based classification systems has begun to transform outcomes for patient subgroups long considered resistant to targeted therapy. | Image Credit: © David A Litman - stock.adobe.com
“If we delve further into exon 20 insertions, we know that they can occur at various different locations within exon 20, including the helical region, the near loop, and the far loop,” Tan said during the WCLC session. “But in the literature, there has been described a large heterogeneity of over 100 different individual insertion variants. This heterogeneity and diversity have complicated therapeutic targeting—historically, at least—and the development of clinical trials.”1
A key biological challenge lies in the structural consequences of exon 20 insertions, according to Tan. These alterations create a smaller adenosine triphosphate–binding pocket that is structurally more similar to wild-type EGFR. As a result, traditional EGFR TKIs fail to achieve selective inhibition, leading to low clinical activity, Tan explained. A meta-analysis published in 2022 confirmed this resistance, reporting a pooled objective response rate (ORR) of only 7% with first-generation EGFR TKIs in patients with exon 20 insertion–mutated NSCLC, Tan explained.1
To address this complexity, a structure–function classification framework was proposed in 2021 by Robichaux et al in Nature.1,2 This system organizes EGFR mutations into 4 categories: classical-like, T790M-like, exon 20 loop insertions, and PACC mutations. Importantly, each subgroup carries different implications for drug sensitivity or resistance. For example, loop-region exon 20 insertions may display partial sensitivity, while helical insertions resemble classical activating mutations. The PACC group encompasses rare but clinically relevant variants in which structural compression drives resistance mechanisms. This classification system serves as a conceptual scaffold for understanding therapeutic selectivity and developing rational treatment strategies, according to Tan.1
Afatinib and early advances. The first notable advance for uncommon EGFR mutations occurred in 2018, when afatinib (Gilotrif; Boehringer Ingelheim), a second-generation irreversible TKI, received label expansion to include specific uncommon mutations such as G719X, S768I, and L861Q. This milestone marked an acknowledgment of heterogeneity within EGFR and the need for mutation-specific strategies, according to Tan. However, activity remained limited for exon 20 insertions, underscoring the ongoing unmet need in this subgroup.1
Amivantamab. Amivantamab (Rybrevant; Janssen Biotech), a bispecific antibody targeting EGFR and MET, represented a paradigm shift in targeting exon 20 insertions.1 Initial approval was granted on May 21, 2021,3 for patients with advanced NSCLC harboring exon 20 insertions following platinum chemotherapy, based on results from the CHRYSALIS phase 1 trial (NCT02609776).1,4 In this study, cohort D evaluated 81 patients, reporting an ORR of 40% (95% CI, 29%-51%) and s median duration of response (DOR) of 11.1 months (95% CI, 6.9-not evaluable). The safety profile was consistent with EGFR-targeted agents, with rash- and infusion-related reactions as the most common toxicities.1
The success of CHRYSALIS led to the phase 3 PAPILLON trial (NCT04538664),5 which investigated first-line amivantamab in combination with carboplatin and pemetrexed vs chemotherapy alone.1 Results were impactful, Tan explained, with the amivantamab arm achieving an ORR of 73% vs 47% with chemotherapy, median progression-free survival (PFS) of 11.4 months vs 6.7 months, and an HR for progression or death of 0.395 (95% CI, 0.300-0.530). These findings secured amivantamab’s first-line approval in combination with chemotherapy and highlighted the promise of bispecific antibodies in exon 20–insertion disease, according to Tan.1
Sunvozertinib. On July 2, 2025, the therapeutic landscape expanded further with the approval of sunvozertinib (Zegfrovy; Dizal Pharma), which is a TKI designed to overcome exon 20–insertion resistance.1,6 Approval was based on the phase 1/2 WU-KONG1 trial (NCT03974022),7 which enrolled patients with platinum-pretreated NSCLC harboring exon 20 insertions. Among 184 patients, the ORR was 46%, with a median DOR of 11.1 months and a median PFS of 13.8 months in the 300-mg cohort. Although the FDA ultimately approved the 200-mg dose, ongoing trials are evaluating sunvozertinib monotherapy in the first-line setting, according to Tan.1
Mobocertinib (Exkivity; Takeda) initially generated enthusiasm with accelerated approval on September 15, 2021,8 for exon 20 insertion–mutated NSCLC after chemotherapy. However, the EXCLAIM-2 phase 3 trial (NCT04129502) failed to demonstrate benefit in the first-line setting, leading to withdrawal of the indication.1,9 This highlights the challenges of translating early activity into durable clinical benefit and the rigorous standards for maintaining regulatory approval, Tan noted.1
Zipalertinib. Zipalertinib (TAS6417; Taiho Oncology and Cullinan Therapeutics),is an investigational EGFR TKI with promising activity in exon 20 insertions. Data from the REZILIENT1 phase 1/2 trial (NCT04036682) reported an ORR of 38%, a median PFS of 10 months, and a median DOR of 10 months among 73 patients.1,10 Common toxicities included rash (80%), diarrhea (30%), and paronychia (32%), consistent with EGFR-targeted agents. Phase 3 studies such as REZILIENT3 (NCT05973773) are ongoing to compare zipalertinib plus chemotherapy vs chemotherapy alone in the first-line setting.1,11
Furmonertinib. Furmonertinib (Ivesa; Allist), another third-generation TKI, has demonstrated substantial efficacy across both treatment-naïve and pretreated cohorts, Tan explained.1 In the FAVOUR phase 1b trial (NCT06643000),12 the ORR was 79% in treatment-naïve patients and ranged from 39% to 46% in previously treated cohorts, depending on dose.1 Median DOR reached 15.2 months in the 240-mg treatment-naïve arm.1 The phase 3 FURVENT trial (NCT05607550) is underway to test furmonertinib monotherapy in the first-line setting.1,13
Although exon 20 insertions have received the most attention, uncommon EGFR mutations such as G719X, L861Q, and S768I, as well as PACC mutations, represent another frontier in precision therapy, according to Tan. Clinical trial data suggest that targeted agents can achieve meaningful activity in these groups, with ORRs ranging from 34.8% to over 70%, depending on the specific alteration and study population. For example, afatinib retains activity in certain uncommon variants, while investigational compounds such as BDTX-1535 and furmonertinib are being explored specifically in PACC or compound mutations.1
An emerging area of investigation is the role of structure–function classification in guiding therapy for these rarer subgroups, Tan noted. By mapping structural features of mutations, such as PACC compression, investigators may be able to predict drug sensitivity and rationalize trial design. However, Tan emphasized that biology often defies neat categorization, and more integrated approaches incorporating genomic, transcriptomic, and microenvironmental insights are needed.1
During his presentation, Tan proposed a conceptual “PACCage insert” framework for clinicians to approach therapy selection in uncommon and exon 20 insertion EGFR mutations. According to Tan, the idea borrows from the regulatory concept of a drug package insert but expands it into a structured guidance document tailored to mutation subtypes. Such a framework would incorporate structural classification, therapeutic evidence, and pipeline updates, while acknowledging the heterogeneity of tumor biology.1
“We still need deeper biological understanding—genomic, transcriptomic, and immune microenvironmental—so that we can better identify precision therapies and tailor modalities for individual patients,” Tan said. “Through this, we can enhance precision approaches for patients with EGFR uncommon or PACC mutations and exon 20 insertions.”1
The treatment landscape for uncommon EGFR mutations and exon 20 insertion–mutated NSCLC is rapidly advancing yet remains defined by complexity and heterogeneity. The emergence of novel TKIs, bispecific antibodies, and structure-based classification systems has begun to transform outcomes for patient subgroups long considered resistant to targeted therapy. The approvals of amivantamab and sunvozertinib represent important milestones, while ongoing investigations of agents such as zipalertinib and furmonertinib hold promise for further expanding therapeutic options.1
However, substantial challenges persist, as Tan noted, including the biological diversity of EGFR alterations, the need for durable efficacy across treatment lines, and the integration of PACC and other rare variants into clinical decision-making. According to Tan, the proposed PACCage insert framework offers a conceptual tool to help clinicians navigate this evolving space, emphasizing mutation-specific strategies informed by structure–function relationships. Moving forward, continued efforts to deepen biological understanding and to align clinical trial design with the nuances of these alterations will be critical to delivering precision therapies that meaningfully improve survival and quality of life for patients with uncommon EGFR-mutated NSCLC.1
References
Exploring Racial, Ethnic Disparities in Cancer Care Prior Authorization Decisions
October 24th 2024On this episode of Managed Care Cast, we're talking with the author of a study published in the October 2024 issue of The American Journal of Managed Care® that explored prior authorization decisions in cancer care by race and ethnicity for commercially insured patients.
Listen